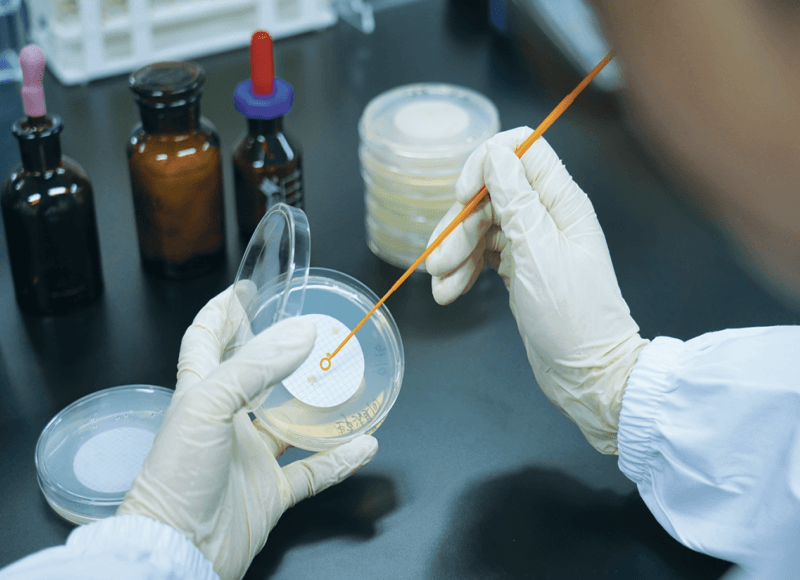
CMEF 2026.04 – Shanghai, China – Booth#7.1W53 (9)

Ritamedtech (Zhongshan) Limited, a subsidiary of Hongrita Group, is excited to announce its participation in the 93rd China International Medical Equipment Fair (CMEF). The event will take place from April 9 to 12, 2026, at the National Exhibition and Convention Center (NECC) in Shanghai.
Since its inception in 1979, CMEF has evolved into one of the world’s leading medical technology exhibitions. As a global “Fortune 500” gathering place and ranked among the world’s top 100 trade shows, the event spans the entire medical industry chain. The 2026 spring exhibition will feature nearly 5,000 exhibitors, showcasing cutting-edge innovations in fields ranging from medical imaging and AI-assisted diagnosis to smart manufacturing.


As a provider of turnkey solutions in Class I–III medical device components and a key player in the upstream sector, Ritamedtech recognizes the critical role of high-quality manufacturing in medical innovation. We will be showcasing our expertise at Booth 5.2F12, located in a dedicated area for medical design and manufacturing. Our exhibit will focus on precision injection molds, customized molding solutions and components in plastic and liquid silicone rubber (LSR) designed specifically for medical device applications.
Ritamedtech established ISO13485 certified quality assurance system with ISO Class 8 GMP workshop and ISO Class 7 GMP laboratory, which are equipped with HEPA-filtered clean air-conditioning system, water purification system, environmental monitoring system and sterilization facilities for production. Meanwhile, we maintain in-house capabilities for sterility testing, bioburden validation and particulate analysis, ensuring controlled and reliable processes. And it leverages Hongrita‘s core expertise in high-precision plastic and liquid silicone rubber (LSR) multi-component molds, unique molding processes and multi-cavity mold technology, combined with advanced digital and intelligent manufacturing capabilities, this integration delivers a highly efficient, full traceable and reliable service that covers product R&D, compliant NPI project management, high-quality mass production and just-in-time delivery.
About spotlights on Tooling:
– We build multi-component, liquid silicone rubber (LSR), cubic mold, stack molds, thin/thick wall molds, high cavitation high performance high precision molds and metal insert molds. They all comply with international standards. We have the capability to build in-house multi-component rotary platen systems. LSR cold runner systems, and quick prototype molds for engineering evaluation. In addition, we offer world class I-stage injection stretch-biow mold (ISBM) tool solution.

(Multi-component Rotary Stack Mold)

(Cubic Mold)
About spotlights on facility:
– ISO Class 8 GMP Workshop

(Automated Sterile Workshop)

(Automated CCD Vision Inspection)
– ISO Class 7 GMP Laboratory.
(Microbiological Experiment)

(Physical Chemistry Experiment) About spotlights on qualifications:





「INVITATION」You are invited to visit our booth to discuss project requirements and explore potential partnerships. Please feel free to schedule a meeting now with us at your convenience and scan below QR CODE to get the free ticket. Our team looks forward to welcoming you in Shanghai.
– Date: April 9 to 12, 2026
– Location: National Exhibition and Convention Center (NECC) in Shanghai.
– Booth: 7.1W53

Media Contact
Company Name: Hongrita
Email: Send Email
Country: China
Website: https://www.hongrita.com/
